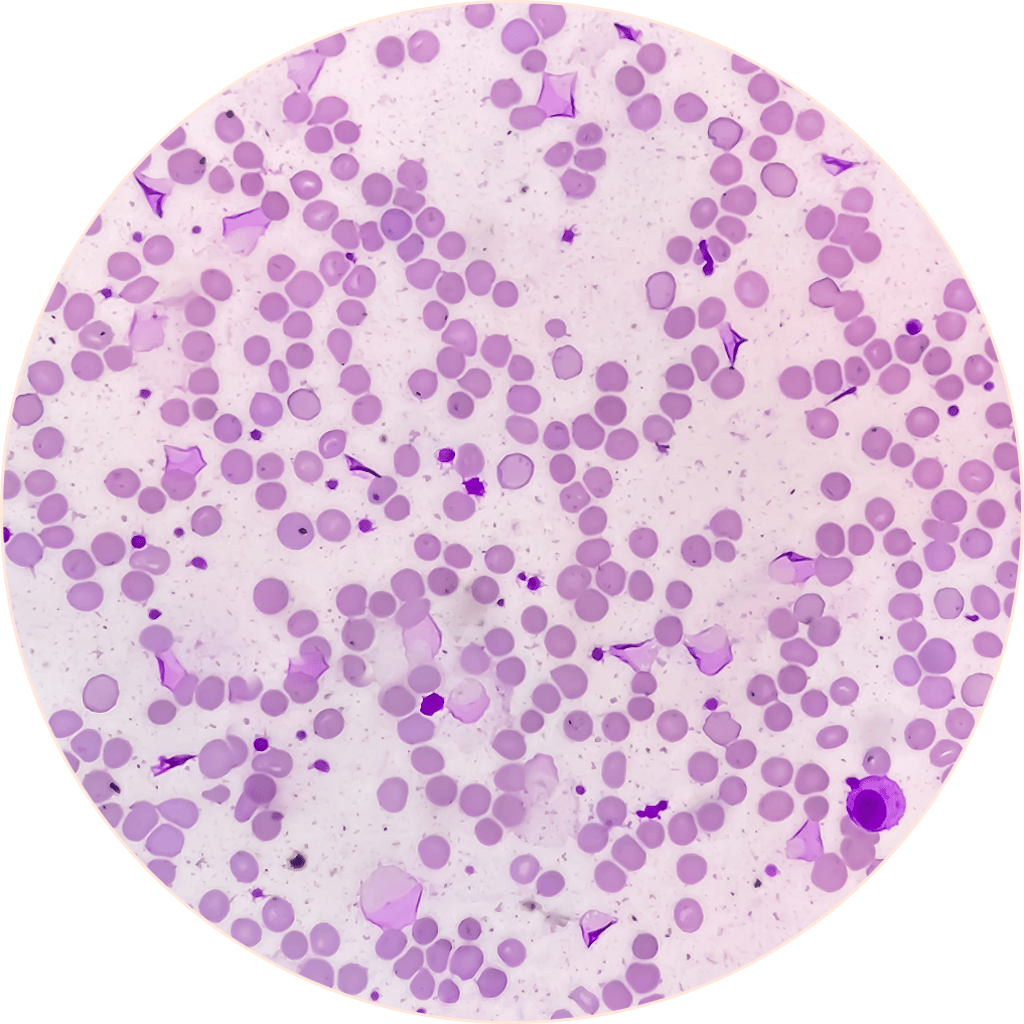
Zdjęcie Zdjęcie

Czy ten produkt jest dla Ciebie?
Wypełnij krótki test, a my Ci podpowiemy.
Odpowiedni poziom żelaza pomaga zachować energię oraz odpowiada za prawidłowy transport tlenu w organizmie oraz wspiera proces podziału komórek. To ważny składnik dla każdej kobiety.
➡️ Dla utrzymania prawidłowego poziomu żelaza¹ rekomendujemy 3-miesięczną suplementację FeMe Complex.
wsparcie produkcji krwi (foliany) oraz krwinek czerwonych (witamina B12) i hemoglobiny (żelazo)
wysoko przyswajalne formy składników
dobrze tolerowany przez układ pokarmowy
To warto wiedzieć o żelazie

[dot] osoby z jego niedoborem
[dot] kobiety w ciąży, miesiączkujące
[dot] wegetarianie oraz osoby z anemią
[dot] kobiety z endometriozą
[dot] osoby po urazach lub operacjach
[dot] osoby z chorobami zapalnymi jelit
[dot] osoby starsze (często z dietą ubogą w żelazo)
[dot] sportowcy i osoby aktywne fizycznie
[dot] osoby z jego niedoborem
[dot] kobiety w ciąży, miesiączkujące
[dot] wegetarianie oraz osoby z anemią
[dot] kobiety z endometriozą
[dot] osoby po urazach lub operacjach
[dot] osoby z chorobami zapalnymi jelit
[dot] osoby starsze (często z dietą ubogą w żelazo)
[dot] sportowcy i osoby aktywne fizycznie
Wspieraj procesy krwiotwórcze
"Niski poziom żelaza powoduje szereg niekorzystnych skutków dla organizmu, między innymi brak energii, zmęczenie czy wypadanie włosów, dlatego warto zadbać o odpowiedni poziom żelaza. Dodatkowo witamina B12 wspiera produkcję krwinek czerwonych, a witamina C zwiększa przyswajanie żelaza."
Ferrytyna też jest ważna
Ilość żelaza we krwi może się wahać w ciągu dnia, dlatego aby sprawdzić rzeczywisty poziom tego pierwiastka należy zbadać również stężenie ferrytyny. To białko, które określa faktyczny zapas żelaza w organizmie.
Kompleksowo i skutecznie
Suplement diety FeMe Complex to ponad 7 składników, które dobraliśmy specjalnie do Twoich potrzeb.
Piękno masz we krwi
Twoja skóra straciła kolor, a włosy mocno się osłabiły? Zadbaj o odpowiedni poziom żelaza. Ekstrakt z pokrzywy zwyczajnej zawarty w suplemencie diety FeMe Complex dodatkowo wspomaga zdrowie skóry i wspiera witalność organizmu.
Potrzebujesz pomocy? Jesteśmy dla Ciebie.
Porozmawiaj z naszym zespołem obsługi klienta. Od poniedziałku do piątku od 8:00 do 21:00.